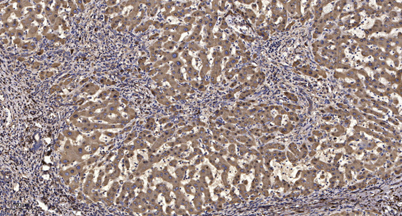

K1551 rabbit pAb
 One-click to copy product information
One-click to copy product information$148.00/50µL $248.00/100µL
| 50 µL | $148.00 |
| 100 µL | $248.00 |
Overview
| Product name: | K1551 rabbit pAb |
| Reactivity: | Human; Mouse |
| Source: | Rabbit |
| Dilutions: | WB 1:500-2000;IHC-p 1:50-300 |
| Immunogen: | Synthesized peptide derived from human K1551 AA range: 262-312 |
| Storage: | -20°C/1 year |
| Clonality: | Polyclonal |
| Isotype: | IgG |
| Concentration: | 1 mg/ml |
| Molecular Weight: | 192kD |
| GeneID: | 55196 |
| Human Swiss-Prot No: | Q9HCM1 |
| Cellular localization: | Nucleus . Localizes around gamma-tubulin during M phase. . |
-
 Western blot analysis of lysates from VEC cells, primary antibody was diluted at 1:1000, 4°over night
Western blot analysis of lysates from VEC cells, primary antibody was diluted at 1:1000, 4°over night -
Immunohistochemical analysis of paraffin-embedded human liver cancer. 1, Antibody was diluted at 1:200(4° overnight). 2, Tris-EDTA,pH9.0 was used for antigen retrieval. 3,Secondary antibody was diluted at 1:200(room temperature, 45min).
Immunohistochemical analysis of paraffin-embedded human liver cancer. 1, Antibody was diluted at 1:200(4° overnight). 2, Tris-EDTA,pH9.0 was used for antigen retrieval. 3,Secondary antibody was diluted at 1:200(room temperature, 45min).

 Manual
Manual